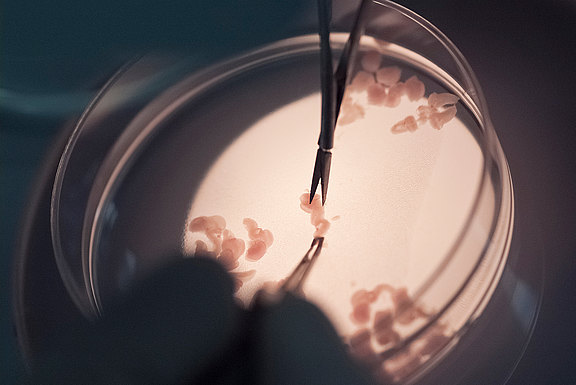
probenentnahme Probenentnahme

Ihr Meister im Fotografenhandwerk
für hochwertige und emotionale Bilder
Professionelle Businessfotografie
Mit professioneller Businessfotografie für Websites und Webshops, für Imagekampagnen auf Social-Media-Kanälen, Print und Werbung präsentieren wir Sie und Ihr Unternehmen. Dabei unterstreichen wir nicht nur Ihre Leistungen, sondern bringen Emotionen rüber und zeigen Ihren Kunden und Geschäftspartnern Ihre Professionalität und Kreativität.
Interaktive Rundgänge für ein besonderes Kundenerlebnis
Durch interaktive Rundgänge bringen wir Sie Ihren Kunden und Partnern näher und ermöglichen einen interessanten und einmaligen Blick in Ihre Verkäufs- und Produktionsräume.
Produkte aussagekräftig in Szene gesetzt
Gebäude im besten Licht dargestellt
spannende Einblicke in wissenschaftliche Themen
erstklassige Fotografie für Web und Print
historische Fotos in neuem Glanz
Besuchen Sie uns auf der mtex- am 29. Mai und 30. Mai 2018 in Chemnitz
Gern beraten wir Sie in einem ersten unverbindlichen Beratungsgespräch zu Ihrem Vorhaben. Gemeinsam entwickeln wir ein Konzept, entsprechend Ihrer Wünsche und Vorstellungen und angepasst an Budget und Ihre Anforderungen!
Nehmen Sie Kontakt auf, wir freuen uns auf Ihre Anfrage!